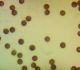

|
Pēdējā augšupielāde 2025-12-20 11:55:19
Все фотографии защищены авторским правом
Последние наблюдения
средний дятел
Leiopicus medius - 2025-12-20 Ara
желтоголовый королек
Regulus regulus - 2025-12-20 Ara
гаичка
Poecile palustris - 2025-12-20 Ara
снегирь
Pyrrhula pyrrhula - 2025-12-20 Ara
галка
Corvus monedula - 2025-12-20 Acenes
лебедь-шипун
Cygnus olor - 2025-12-20 Lietuviete
лазоревка
Cyanistes caeruleus - 2025-12-20 Ara
|
Последние комментарии novērojumiem
Vīksna Mari Paldies, Julita! Jauki, ka tomēr izdevās tikt līdz sugai! :)) Prieks! Netipisks augšanas laiks. Ja būtu paraugs, tad pārbaudītu. Jā, ragansviests tas ir pilnīgi noteikti. Var būt arī dzeltenais. adata Vīksna ekologs ekologs Orchesella sp. Iespējams Orchesella flavescens. adata adata Paldies, Julita! Tad šīs var augt ne tikai uz skujkokiem. Ziemelmeita Raupjā sīkpiepe noteikti nav. Derētiu tuvāku attēlu, lai varētu padomāt par sugu adata adata Redz stiklaini gļotainu kājiņu. adata Varētu būt nabas jāņodzīte, tik nav pārliecības, jo neredz virspusē raksturīgo "diskiņu". Osis Amanda Visas atēlā redzamās ir kanādas zosis. VijaS Osis 1 tiešām, vai pārējas ar var traktēt kā Kanādas zosis? Amanda VijaS VijaS VijaS mufunja Varbūt es kļūdos. Man ir fotogrāfija, bet nav parauga:( zemesbite Vīksna Palikšu pie ticamākiem novērojumiem un bildēm.Vismaz kukaiņu diezgan un var ar bildēm likt. Ivars Leimanis Parastā sprogaine Ulota intermedia Amanda Atlanta pazīmes, tajā skaitā "T", domātas tikai putniem. ekologs Jā, strupaste. Manuprāt, tumšā strupaste (Microtus agrestis). gunitak Amnis77 Uzvedība ligzdotājam, Ilze. Viņi šeit vairojas!!! adata Jautājums Julitai, vai augu vālenītes var būt gan dzeltenu, gan baltu plazmodiju? Vīksna Mary1979 12.decembris, 15:31 Mari adata Un tas plazmodijs, tiešām tāds Mmmm! adata Mari Oho, paldies Julita!! Šis gan ir pārsteigums! :)) Marita, apsveicu, Tev šogad izcili atradumi!! Ziemelmeita mufunja mufunja viņš nobriedis mājās un pārvērties par Dzeltenais ragansviests :) kamene Paldies, Julita, par visiem ragansviestiem! Šis arī nav Tas bēšais, kaut tonis nešaubīgi nav parastais baltais. Bēšajam ir maza un bēšīga pakāje. Domāju, ka šis drīzāk agri savecējis baltais. Apskatījos, jā, tā pati situācija, mums aug ne-pēcsniedzītes ar pēcsniedzīšu sporu izmēriem. Ivars Leimanis https://www.britishbryologicalsociety.org.uk/wp-content/uploads/2020/12/Lophocolea-heterophylla.pdf Vīksna Osis ekologs Varētu būt kāds dumbrainis (Cyphon sp.). Vīksna Šis paraugs nav saglabājies, kam sporas izmērīt? Būtu vērtīgi. Tur no iekšām nespīd kas dzeltens? Pakāje izskatās rozīga. Plus oktobris un augšana uz vertikāla stumbra velk uz licentii adata Mary1979 10.decembris, 06:44 https://www.youtube.com/watch?v=-Hast6NBnTM Mary1979 10.decembris, 06:43 https://www.youtube.com/watch?v=25-zw8qZ4J8 VijaS Nevar izslēgt tādu varbūtību. Bet parauga nav, nepārbaudīšu. VijaS VijaS Jā, piekrītu, visticamāk tā arī ir. Vīksna VijaS Tā pirmā bilde!! Paradīzes mežs.. Kur tieši tas ir novērots? Man ir aizdomas, ka tur Rīgā nav tik skaists mežs kā izskatās foto. Kāda gludā atliekas nevar būt? Noteikt plazmodiju līdz sugai tomēr ir riskanti, turklāt sugai netipiskā laikā :) Vai nevar būt paliekas no kāda gludā? Pēc novērojuma laika (rudens) ticamāks ir gludais, kuru tādu pusjukušu no rūsganā pagrūti atšķirt Amanda Brūnbaltais ir sēne. Par sarkano pa gabalu nevar saprast, kas tas ir. Izskatās gluda un spīdīga virsma, tad būtu jābūt gludo grupai, kas jāmikroskopē Ļoti tumšas iekšas, nav rūsganā toņa. Rūsganā pakāje toties stīgo Jautājums, vai šis nav dzeltenais.. Ivars Leimanis Ivars Leimanis Vairāk pēc Antrodia albida izskatās. Kā es sasmējos - titulbilde kādai kriminālziņai :DD adata Mari Ja šim būtu paraugs, tad būtu lieliski paskatīt, cik tādam sporas lielas. Ja ir paraugs, var pārbaudīt, bet es domāju, ka flava Mareks Kilups Mareks Kilups tikai balss, tā kā jāvērtē, vai ticami. šorīt te ir daudzas, bet visas akmeņu čipstes. AgneseČamane Paldies! Bija aizdomas par citronu bisporellu, bet nebiju droša. VijaS Mari Tagad galvenais uzdevums saprast, ar ko šī dzeltenā stadija atšķiras no licentii.. MJz VijaS Jā, pakāje tiešām raiba, šoreiz foto toņi diezgan precīzi atbilst dabā redzētajam. VijaS Hm, kad Tu tā saki, tad jā, var saskatīt. Bet citādi ļoti neuzkrītošas.. VijaS Mari adata Es te sajaucu abas sugas vietām. Izskatās luteonitens! Mari Pievienoju vēl vienu sporu foto Mari Sporām man arī šķita viena puse gaišāka, kā arī kārpas skraji un neregulāri izvietotas :) Vai arī vēl labāk, laevis, ja sporām kārpas ir skraji un neregulāri izvietotas Šis no gludo grupas. Man izskatās, sporām viena puse gaišāka? Tad luteonitens :) Mari Mari Te gan krāsa interesanta! Varbūt paliekas no rūsganā ragansviesta. Tagad jau vairs nepateiks. Jocīgi. Tik košs dzeltenais, bet tak rūsgana nekā nav tajā beigu stadijā. Ievākts nav? No tāda plazmodija vēl sugu pateikt nevar. Var būt arī Physarum Pagaidām lai paliek kā Leiopus nebulosus/linnei, ja vien nav ievākts un pārbaudīts zem mikroskopa. mufunja Diemžēl 2019. gadā es neievācu nevienu paraugu. adata A ko, ja aptrūkās sērkociņu... adata Tā, kā dzeltens būtu zaudējis krāsu, ne baltais. adata Dzeltena, ja nebūtu pārliecināta par krāsu novērošanas brīdī, būtu likusi nenoteiktu. Un tās paštaisītās kastītes! :)) adata Iekšas gan nepaskatījos, ja ir aizdomas, var mainīt sugu. adata Skaidrs, tad var būt arī šādi sarkani, ne vienmēr apšu beku krāsā. adata Dzeltena, jau pabalējusi "augšiņa". Būs parastākā suga, bet paldies par paraugu! Ļoti smukas sporas :) Kāpēc šim ir doma par dzelteno? Liels paldies! :) Tieši tāpēc, ka ir tik ilgi, ir īpaši interesanti. zemesbite Vilnis Skuja uzskata, ka lapsa - "lapsas gaita un purns". Kašķainu asti varot neredzēt šajā video. DaceK Ivars Leimanis ekologs Mežirbe777 Paldies par vērību, Edgar! Piezīmēs koordinātas tika precizētas. Bekuvecis 05.decembris, 19:14 Bekuvecis 05.decembris, 19:09 Bekuvecis 05.decembris, 18:58 Bekuvecis 05.decembris, 18:52 adata adata Jā, nebija nobriedis. Vēl "mīksts", bail bija, ka lietū neizšķīst. zemesbite Jā, Julita, tiešām bija bēšs. :) zemesbite Ziemelmeita Vladimirs S Vladimirs S Jautājums tikai, vai tiešām bija bēšs, varbūt bija balts, tikai tumšāk nobildējies? Vladimirs S Gunitiii 05.decembris, 09:59 Video https://failiem.lv/u/stwzdsh6bt Vīksna ekologs Stopējot kadrus, var redzēt, ka seja ir izstiepta, gareneska. Iespējams video kvalitātes jautājumi kamene Paldies, Ansi! Vajadzēs vēlreiz to kļavu pie stacijas labāk apskatīt. Jānis Ozoliņš un Valdis Pilāts uzskata, ka lūsis - izkāmējis lūsēns. zemesbite Mari Nē, diemžēl sporas toreiz nenomērīju. Vīksna |